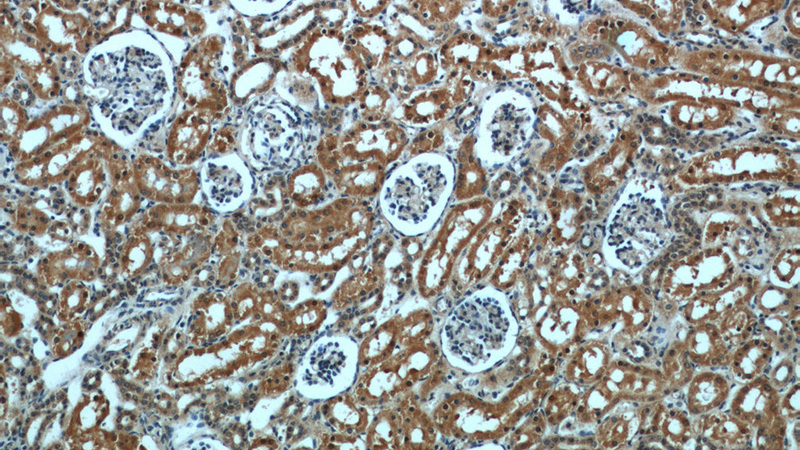
Immunohistochemical of paraffin-embedded human kidney using Catalog No:114467(RPTOR antibody) at dilution of 1:50 (under 10x lens)
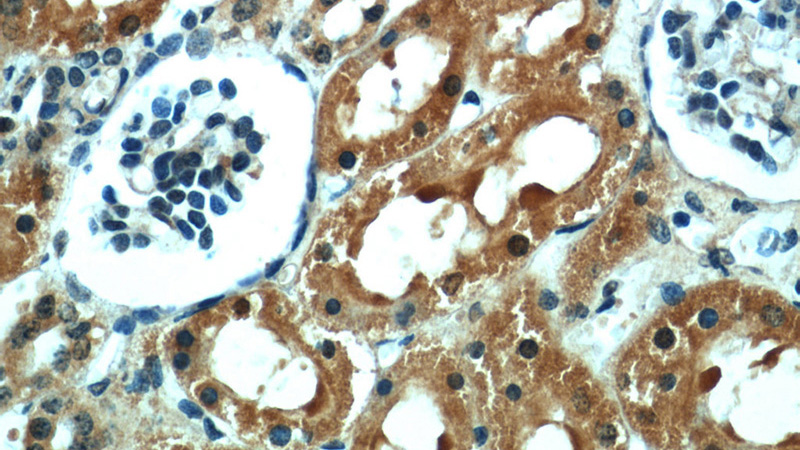
Immunohistochemical of paraffin-embedded human kidney using Catalog No:114467(RPTOR antibody) at dilution of 1:50 (under 40x lens)

-
Product Name
Raptor antibody
- Documents
-
Description
Raptor Rabbit Polyclonal antibody. Positive WB detected in HepG2 cells, HeLa cells, MCF7 cells. Positive IP detected in HeLa cells. Positive IHC detected in human kidney tissue, human skeletal muscle tissue. Positive IF detected in HeLa cells. Observed molecular weight by Western-blot: 130-150 kDa
-
Tested applications
ELISA, WB, IHC, IP, IF
-
Species reactivity
Human, Rat; other species not tested.
-
Alternative names
KIAA1303 antibody; raptor antibody; RPTOR antibody
-
Isotype
Rabbit IgG
-
Preparation
This antibody was obtained by immunization of Peptide (Accession Number: NM_020761). Purification method: Antigen affinity purified.
-
Clonality
Polyclonal
-
Formulation
PBS with 0.02% sodium azide and 50% glycerol pH 7.3.
-
Storage instructions
Store at -20℃. DO NOT ALIQUOT
-
Applications
Recommended Dilution:
WB: 1:500-1:5000
IP: 1:500-1:5000
IHC: 1:20-1:200
IF: 1:20-1:200
-
Validations

HepG2 cells were subjected to SDS PAGE followed by western blot with Catalog No:114467(RPTOR antibody) at dilution of 1:1000

IP Result of anti-Raptor (IP:Catalog No:114467, 4ug; Detection:Catalog No:114467 1:1000) with HeLa cells lysate 1505ug.
Immunohistochemical of paraffin-embedded human kidney using Catalog No:114467(RPTOR antibody) at dilution of 1:50 (under 10x lens)
Immunohistochemical of paraffin-embedded human kidney using Catalog No:114467(RPTOR antibody) at dilution of 1:50 (under 40x lens)

Immunofluorescent analysis of HeLa cells using Catalog No:114467(Raptor Antibody) at dilution of 1:50 and Alexa Fluor 488-congugated AffiniPure Goat Anti-Rabbit IgG(H+L)
-
Background
RPTOR, also named as KIAA1303 and RAPTOR Belongs to the WD repeat RAPTOR family. It is involved in the control of the mammalian target of rapamycin complex 1 (mTORC1) activity which regulates cell growth and survival, and autophagy in response to nutrient and hormonal signals; functions as a scaffold for recruiting mTORC1 substrates. mTORC1 is activated in response to growth factors or amino-acids. Amino-acid-signaling to mTORC1 is mediated by Rag GTPases, which cause amino-acid-induced relocalization of mTOR within the endomembrane system. Activated mTORC1 up-regulates protein synthesis by phosphorylating key regulators of mRNA translation and ribosome synthesis. mTORC1 phosphorylates EIF4EBP1 and releases it from inhibiting the elongation initiation factor 4E (eiF4E). mTORC1 phosphorylates and activates S6K1 at 'Thr-389', which then promotes protein synthesis by phosphorylating PDCD4 and targeting it for degradation. The antibody is specific to RPTOR.
-
References
- Li Z, Xu G, Qin Y. Ghrelin promotes hepatic lipogenesis by activation of mTOR-PPARγ signaling pathway. Proceedings of the National Academy of Sciences of the United States of America. 111(36):13163-8. 2014.
- Wu X, Dou Y, Yang Y. Arctigenin exerts anti-colitis efficacy through inhibiting the differentiation of Th1 and Th17 cells via an mTORC1-dependent pathway. Biochemical pharmacology. 96(4):323-36. 2015.
- Wang H, Chen Y, Lu XA, Liu G, Fu Y, Luo Y. Endostatin Prevents Dietary-Induced Obesity by Inhibiting Adipogenesis and Angiogenesis. Diabetes. 64(7):2442-56. 2015.
Related Products / Services
Please note: All products are "FOR RESEARCH USE ONLY AND ARE NOT INTENDED FOR DIAGNOSTIC OR THERAPEUTIC USE"
